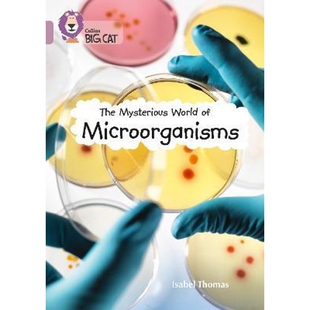

食品腐败微生物 Microorganisms 海外直订Food Spoilage
¥2191满999减100售0件

Enzymes Inhibitors from Microorganisms 酶 海外直订Zinc 锌酶抑制剂:来自微生物 Enzyme
¥2208满999减100售0件

Plants and Rhizospheric 海外直订Iron 植物和根际微生物 Microorganisms 铁营养 Nutrition
¥2208满999减100售0件

微生物 未培养 海外直订Uncultivated Microorganisms
¥2274满999减100售0件

Plants and Rhizospheric 植物铁营养与根际微生物 海外直订Iron Microorganisms Nutrition
¥2274满999减100售0件

海外直订Uncultivated 未培养微生物 Microorganisms
¥2274满999减100售0件

for Green 海外直订Biopolymers 绿色未来 Microorganisms Futu... 微生物生物聚合物 from
¥2287满999减100售0件

Agriculture 农业有益微生物 Microorganisms 海外直订Beneficial
¥2299满999减100售0件

食物中 海外直订Microorganisms Foods 微生物7
¥2299满999减100售0件

Enzymes from Microorganisms 海外直订Zinc 来自微生物 Inhibitors 锌酶抑制剂 酶 Enzyme
¥2377满999减100售0件

Bioactive for Compounds from 从微生物中寻找生物活性化合物 海外直订The Microorganisms Search
¥2386满999减100售0件

and Microorganisms Aspects Application Fundamental 海外直订医药图书Proteomics
¥2386满999减100售0件

Impacts 微生 and Environments Diversity Work Home Indoor 家庭和室内工作环境中 海外直订Microorganisms Health
¥2410满999减100售0件

9789814322102 Industry Environment and 按需印刷Microorganisms
¥2538满800减100售0件

for 海外直订Microorganisms Assessing and Control Foods Product Use Process Data
¥2575满999减100售0件
World Microorganisms Band Pearl 预订The Mysterious
¥156满100减6售0件

Traditional 海外直订Microorganisms Fermentation Foods and
¥2618满999减100售0件

Microorganisms 微生物分子系统发育学 Phylogeny 海外直订Molecular
¥2641满999减100售0件

Microorganisms 研究 ABC转运蛋白 Transporters Targets Innovation Research 微生物中 海外直订ABC and Value
¥2641满999减100售0件

低温微生物 Microorganisms 海外直订Cold Adapted
¥2641满999减100售0件

海外直订Thermophilic 嗜热微生物 Microorganisms
¥2641满999减100售0件

Scientific 微生物:从科 Industry 工业和环境中 Resea Industrial From Environment and 海外直订Microorganisms
¥2691满999减100售0件

New 植物和微生物合成异戊二烯 Experimental Concepts Microorganisms and Plants Synthesis 海外直订Isoprenoid
¥2894满999减100售0件

New 合 植物和微生物中异戊二烯 Experimental Concepts Microorganisms and Plants Synthesis 海外直订Isoprenoid
¥2894满999减100售0件

锰矿微生物 Microorganisms 海外直订Manganese Mining
¥3037满999减100售0件

with Control Microorganisms Pollution 预订Chemical
¥3092满800减100售0件

Biopesticides Beneficial 微生物生物杀虫剂 配方:有 and Microbial Nematodes 海外直订Formulation Microorganisms
¥3101满999减100售0件

Biopesticides Beneficial 微生物生物杀虫剂 配方:有 and Microbial Nematodes 海外直订Formulation Microorganisms
¥3101满999减100售0件

Termites and Other 海外直订Intestinal 白蚁和其他无脊椎动物 Invertebrates 肠道微生物 Microorganisms
¥3101满999减100售0件

Homeostasis and Microorganisms 按需印刷Iron 9781904455653 Uptake
¥3145满800减100售0件